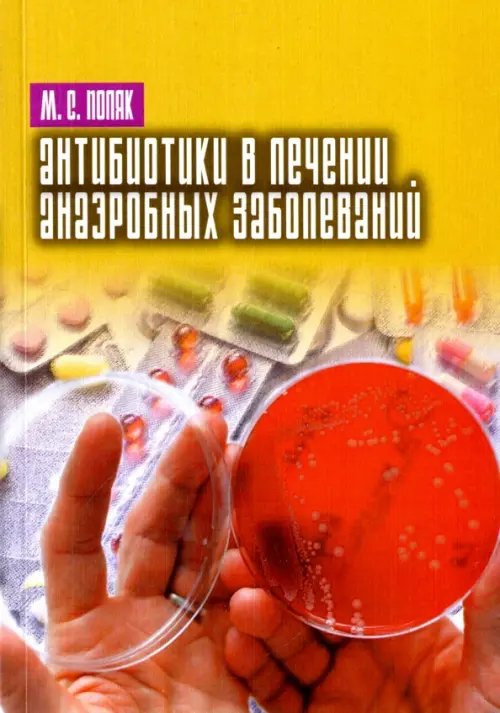
Антибиотики в лечении анаэробных заболеваний

Аннотация: Антибиотики в лечении анаэробных заболеваний
Антибиотикотерапия является важным компонентом комплекса лечебных мероприятий при заболеваниях, вызванных облигатно анаэробными бактериями (родов Bacteroides, Prevotella, Porphyromonas, Clostridiumи др. ). На ее эффективность существенно влияют как особенности возбудителя патологии, так и самого процесса. Среди них: своеобразие чувствительности анаэробов к антибиотикам; нарастающая вторичная устойчивость к ним бактерий; тяжесть и быстрое развитие патологического процесса с обширной деструкцией тканей; смешанный характер микрофлоры и многое другое. Эти вопросы обсуждаются в книге. Обращено внимание на ограниченность лабораторного (микробиологического) обеспечения антибиотикотерапии анаэробных инфекций. Обобщена практика применения антибиотиков при заболеваниях, вызванных облигатно анаэробными микроорганизмами.
| Автор/составитель | Поляк Марк Соломонович |
| Год выпуска | 2017 |
| ISBN | 978-5-4469-1149-3 |
| Производитель | Нестор-История |
| Издательство | Нестор-История |
| Количество томов | 1 |
| Количество страниц | 192 |
| Переплет | Мягкая обложка |
| Размеры | 198x137x11 мм |
| Цвет | Жёлтый |
| Тип бумаги | офсетная (60-220 г/м2) |
| Формат | 60x90/16 (145x215 мм) |
| Стандарт | 10 |
| Вес | 226 |
| Язык | русский |
Бесплатная Доставка по Европе (EU)*
*Для заказов свыше 40, - евро Подробнее
Антибиотики в лечении анаэробных заболеваний
- Производитель: Нестор-История
- Модель: MYSH4842105
- ISBN: 978-5-4469-1149-3
- Наличие:
-
Срок доставки: 21 день
- (9 оценок)